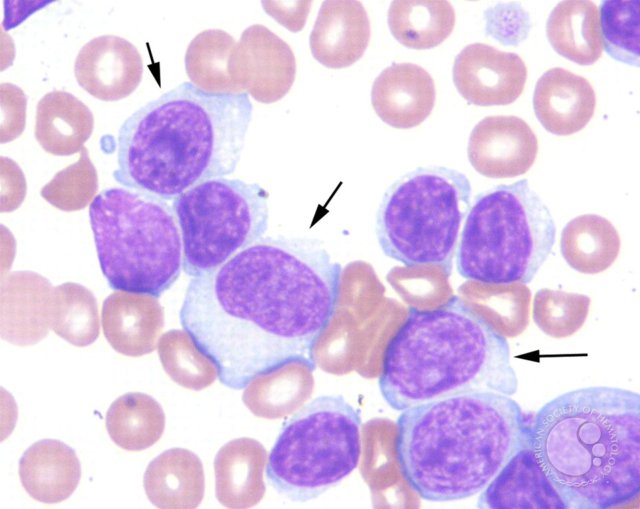
Хронический лимфобластный лейкоз

Рак – собирательное название для большой группы заболеваний. Эти болезни действуют примерно одинаково – они замещают здоровые ткани организма своими бесполезными или вредными клетками, из-за чего орган или структура не могут полноценно работать. Один из видов рака – лейкоз – поражает кровь (она тоже является тканью, только жидкой). Лейкоз имеет множество названий: лейкозы острые и хронические, ОМЛ, ОЛЛ и т.д. Статья призвана описать основные виды и классификации лейкоза.
Вкратце о лейкозе
Лейкоз (он же «лейкемия» или «белокровие») – злокачественная болезнь крови. В последней появляются «неправильные» клетки, которые не выполняют своих функций. Как следствие – анемия, тромбоцитопения, угнетение иммунитета и другие сопутствующие болезни.
Врачи отмечают, что классификация лейкозов играет ключевую роль в диагностике и лечении этого заболевания. Существует несколько основных типов лейкозов, которые делятся на острые и хронические формы, а также на лимфобластные и миелоидные. Острые лейкозы характеризуются быстрым прогрессированием и требуют немедленного вмешательства, тогда как хронические формы могут развиваться медленнее и иногда остаются бессимптомными на протяжении длительного времени. Врачи подчеркивают важность точной классификации для выбора оптимальной терапии, так как разные типы лейкозов могут требовать различных подходов к лечению. Кроме того, современные методы молекулярной диагностики позволяют более точно определить подтипы лейкозов, что значительно улучшает прогноз для пациентов. Таким образом, правильная классификация лейкозов является основой для эффективного лечения и повышения качества жизни больных.
https://youtube.com/watch?v=kvzoTyy60Gk
Простая классификация
Простая классификация лейкозов делит их на острые и хронические.
Острый лейкоз означает, что в кровь поступает много незрелых (на зародышевой стадии) кровяных или других телец, которые своей массовостью вытесняют здоровые клетки. Болезнь имеет 3 фазы течения:
- Начальная, практически бессимптомная.
- Развернутая, при которой появляются все клинические симптомы.
- Терминальная, при которой пациента практически гарантированно ожидает смертельный исход.
В развернутой фазе решается вопрос жизни пациента – если терапия помогла, то болезнь уходит в ремиссию, если нет, то наступает терминальная фаза.
Хронический лейкоз имеет другую картину. При нем в крови образуются полноценные клоны – клетки, которые имеют такую же структуру, как и здоровые, но при этом не выполняют своих функций (бласты). Хронический лейкоз развивается на протяжении длительного времени. Не имеет начальных проявлений, поэтому чаще всего обнаруживается случайно, когда пациент сдает анализ крови на что-нибудь другое. Пока существует только один вид клонов – прогноз благоприятный, течение болезни легкое. Но когда появляются вторичные клоны, болезнь начинает очень быстро прогрессировать, выживаемость составляет 20%.
Нужно отметить, что понятия «острый» и «хронический» в случае с лейкозом не означают то же самое, что и при обычных болезнях. Острый лейкоз никогда не перейдет в хронический лейкоз, и наоборот. Эти болезни – разные, у них много отличий. «Острый» и «хронический» используется медиками для удобства классификации.
Сложная классификация (на основании цитогенеза)
Цитогенез – это наука о развитии клеток. На ее основании была выдвинута классификация, которая точно описывает виды лейкозов. Каждому из этих видов соответствует компонент в крови, который стал причиной болезни.
Классификация лейкозов вызывает много обсуждений среди медицинских специалистов и пациентов. Многие отмечают, что четкое понимание различных типов лейкозов помогает в выборе наиболее эффективного лечения. Врачи подчеркивают важность различия между острыми и хроническими формами, так как это влияет на прогноз и подход к терапии. Пациенты, в свою очередь, часто выражают беспокойство по поводу сложных медицинских терминов и стремятся получить доступную информацию о своем заболевании. Некоторые исследователи акцентируют внимание на генетических и молекулярных характеристиках, которые могут помочь в более точной классификации и индивидуализации лечения. В целом, обсуждение классификации лейкозов подчеркивает необходимость междисциплинарного подхода и активного вовлечения пациентов в процесс принятия решений о лечении.
Острый миелобластный лейкоз
Этой болезни чаще всего подвержены люди пожилого возраста.
Причины возникновения
Виновником заболевания становится миелобласт – частично дифференцированная стволовая клетка.
Диагностика
Для диагностики нужна пункция костного мозга, результат которой впоследствии окрашивают красителями и исследуют.
Течение
При ОМЛ сначала появляется анемия, так как миелобласты вытесняют собой нормальные кровяные тельца. Затем присоединяется нейтропения, которая провоцирует небольшие кровоизлияния в слизистых оболочках и развитие различных инфекций. В развернутой фазе нейтропения приводит к появлению инфарктов и множественных вторичных инфекционных болезней. Температура тела – высокая.
Острый лимфобластный лейкоз
Эта болезнь крови сильно бьет по иммунитету.
Основной мишенью становятся лимфоциты. Перед тем, как стать полноценными защитниками иммунитета, лимфоциты должны созреть из лимфобластов. При остром лимфобластном лейкозе лимфобласты не успевают развиться, и в кровь вместо полноценных клеток поступают бесполезные зародыши.
Пункция костного мозга или анализ крови. Если костный мозг на треть состоит из бластов – диагноз подтверждается. Если во взятом анализе крови было обнаружено такое же количество бластов – диагноз могут подтвердить без пункции.
ОЛЛ вызывает много сопутствующих ему болезней:
- анемия;
- множественные кровотечения;
- многочисленные вирусные/грибковые/бактериальные болезни и их последствия;
- увеличение размера лимфоузлов, печени и селезенки, костного мозга;
- сильное снижение иммунитета.
Изредка из-за этого лейкоза страдают почки, и происходит это бессимптомно.
https://youtube.com/watch?v=sPpOMNFhANA
Острый недифференцированный лейкоз
Группа лейкозов, не поддающихся классификации.
Причины ОНЛ чаще всего неизвестны. Единственное, что понятно – в кровь поступает огромное количество недоразвитых клеток, природу которых не удается установить.
Анализ крови, пункция костного мозга на предмет атипичных клеток.
Острый недифференцированный лейкоз считается самым сложным и опасным среди острых лейкозов. Он развивается очень быстро, продолжительность жизни пациентов с таким диагнозом – от 1 до 6 месяцев, редко – до года. Симптомы – сильная интоксикация, лихорадка. ОНЛ очень плохо поддается лечению.
Хронический миелобластный лейкоз
Лимфобластный и миелобластный лейкозы – самые распространенные, на них приходится до 80% случаев.
Нарушение в клетках костного мозга приводит к тому, что в костном мозгу образуется опухоль, которая производит лейкоциты. Как следствие, зернистые лейкоциты (самые распространенные лейкоциты в крови) начинают поступать в кровь в избытке. Кроме того, «опухолевые» лейкоциты живут в 10 раз дольше, чем обычные.
Анализ крови на количество лейкоцитов, дифференциальная диагностика.
Различают две стадии:
- На доклинической стадии болезнь никак себя не проявляет. Существует только один достоверный симптом – немотивированное повышение количества лейкоцитов в крови. Изредка у пациента увеличивается селезенка. На этой стадии болезнь обычно обнаруживают случайно во время анализа крови.
- На развернутой стадии появляется усталость и потливость, повышается температура тела. Увеличиваются селезенка и печень. Возможны инфаркт селезенки и желтуха. Нарастает анемия.
ХМЛ неплохо поддается лечению химиотерапией – под ее воздействием часто наступает стойкая ремиссия.
Хронический лимфобластный лейкоз
Эта лейкемия развивается преимущественно у пожилых и имеет длительное течение.
Причины возникновения лейкоза, связанного с лимфой, в том, что опухоль поражает лимфатические узлы и селезенку, после чего в кровь поступают опухолевые лимфоциты.
Анализ крови на лимфоциты.
Хроническая лимфобластная лейкемия протекает очень медленно. Поэтому на ранних стадиях его даже не пытаются лечить – при небольшом повышении количества лимфоцитов в крови пациент не чувствует признаков болезни. Проблемы начинаются тогда, когда раздуваются лимфоузлы и селезенка (что может вызывать дискомфорт и даже боль), возникают тромбоцитопения и анемия. В дополнение к этому пациент начинает ощущать опухолевую интоксикацию – ночной пот, постоянная слабость, повышенная утомляемость.
Методы лечения довольно разнообразные:
- биоиммунотерапия;
- химиотерапия;
- лучевая терапия;
- спленэктомия;
- пересадка здоровых фракций крови.
Прогноз довольно благоприятный.
Хронический моноцитарный лейкоз
Эта лейкемия – крайне скрытная.
Как следует из названия, при этом лейкозе в крови сильно увеличивается количество моноцитов – одноядерных лейкоцитов.
Эту болезнь крайне сложно диагностировать, так как она имеет очень мало проявлений. В первые 5 лет после заболевания даже не меняется формула крови. Верные лабораторные признаки, по которым можно заподозрить хроническую моноцитарную лейкемию: повышение уровня моноцитов в крови, увеличение скорости оседания эритроцитов (СОЭ) и повышенный уровень лизоцима в моче.
При легком течении пациент не чувствует никаких проявлений болезни, посему лечение не требуется. При появлении анемии и цитопении проводится симптоматическое лечение. Только на последней стадии необходимо серьезное лечение – такое же, какое применяется и при острых лейкозах.
Макрофагальный лейкоз
Опасный и малоизученный диагноз.
Как и в случае с острым недифференцированным лейкозом, происхождение лейкоза в данном случае представляет собой загадку медицины. Только в последние 40 лет медики начали выделять странную форму лейкоза, которую, несмотря на ее быстрое течение, условно отнесли к хроническим. Позже врачи нашли косвенные подтверждения того, что в макрофагальном лейкозе виновны мутировавшие макрофаги.
Макрофагальная лейкемия обладает симптомами, которые могут принадлежать как другиvм лейкозам, так и вообще заболеваниям из других сфер. Самый распространенный подход – слежение за температурой тела. Если последняя постоянно поднимается без видимых причин, есть повод заподозрить эту форму лейкоза. Дальше диагноз уточняется методом исключения.
Лейкемия быстро «съедает» пациента, 20 лет назад средняя продолжительность жизни больных с этим диагнозом составляла 7-9 месяцев. Основные проявления: высокая температура тела, нарастающие слабость и усталость, увеличенные селезенка и печень, желтуха. Часто болезнь сопровождается плевритом, перикардитом, крупными зудящими вздутиями на коже.
Лечение – медикаментозное, пока что подбирается экспериментально из нескольких медикаментов. Есть данные о ремиссиях средней длительности после лечения.
Лечение
Пока что самым действенным видом лечения рака крови является химиотерапия. Через капельницу пациенту вводят специальные препараты, останавливающие развитие опухолевых клеток. Лечение зависит от видов лейкемии, но в среднем длится 2 месяца в условиях больницы и до полутора года – в домашних условиях.
В больнице за пациентом тщательно следит лечащий врач – он постоянно назначает анализы для того, чтобы понять, эффективны ли данные препараты. Если нет – ищет другую комбинацию. Этот период очень сложен для больного, так как химиотерапия имеет много неприятных побочных эффектов – рвота, головная боль, усталость, выпадение волос. Кроме того, химиотерапия практически полностью убивает иммунитет, поэтому пациента изолируют от окружающего мира в палате и предписывают ему строгое соблюдение гигиены.
https://youtube.com/watch?v=BcB2mElFWwA
В домашних условиях «режим» немного слабее, но все же присутствует. Больному нужно соблюдать диету, нормально спать, отказаться от телевизора и часто гулять на свежем воздухе. Раз в несколько недель – появляться у врача для осмотра, анализов и получения дальнейших распоряжений.
Вероятность выздоровления далеко не стопроцентная, но раковые заболевания – одна из самых быстрорастущих областей медицины, и каждый месяц появляются новые методы и лекарства, которые если и не полностью исцеляют больного, то, по крайней мере, продлевают его жизнь на годы и даже десятки лет.
Лейкемия – это группа злокачественных болезней крови, объединенных одним общим проявлением – возникновением в крови бесполезных или вредных клеток. Отличия лейкозов – в клетках, которые оказываются пораженными. Лейкозы бывают острыми и хроническими, хотя для них это разделение не означает, что одни могут «перетечь» в другие. Некоторые лейкозы на ранних стадиях не требуют лечения, другие же нуждаются в срочной и интенсивной химиотерапии. Шанс стойкой ремиссии есть практически всегда.
Вопрос-ответ
Как можно классифицировать лейкозы?
Лейкозы делятся на четыре основных типа: острый лимфобластный лейкоз, острый миелоидный лейкоз, хронический лимфолейкоз.
Как классифицируется лейкемия?
Лейкоз – гетерогенная группа гематологических злокачественных заболеваний, возникающих вследствие дисфункциональной пролиферации развивающихся лейкоцитов. В зависимости от скорости пролиферации лейкозы классифицируются как острые или хронические, а в зависимости от клеток-источников – как миелоцитарные или лимфоцитарные.
Какова классификация ОМЛ?
Классификация органических молекулярных лекарств (ОМЛ) может быть основана на различных критериях, таких как химическая структура, механизм действия, терапевтическое применение и фармакологические свойства. Основные группы включают антибиотики, противовирусные, противогрибковые, противоопухолевые и противовоспалительные препараты, а также препараты для лечения сердечно-сосудистых, эндокринных и нервных заболеваний.
Что такое лейкоз 4 степени?
4 стадия характеризуется образованием вторичных опухолей, сопровождающимся быстрым увеличением количества гемопоэтических клеток. Это приводит к развитию наиболее тяжелой стадии лейкемии и связанных с заболеванием осложнений.
Советы
СОВЕТ №1
Изучите основные типы лейкозов, такие как острый и хронический, а также их подтипы. Понимание различий поможет вам лучше ориентироваться в диагнозах и методах лечения.
СОВЕТ №2
Обратите внимание на симптомы, которые могут указывать на лейкоз, такие как усталость, частые инфекции и необъяснимые кровотечения. Раннее обращение к врачу может существенно повысить шансы на успешное лечение.
СОВЕТ №3
Не стесняйтесь задавать вопросы своему врачу о диагнозе и лечении. Понимание вашего состояния и доступных вариантов терапии поможет вам принимать более информированные решения.
СОВЕТ №4
Поддерживайте здоровый образ жизни, включая сбалансированное питание и регулярные физические нагрузки. Это может помочь укрепить иммунную систему и улучшить общее состояние здоровья во время лечения.